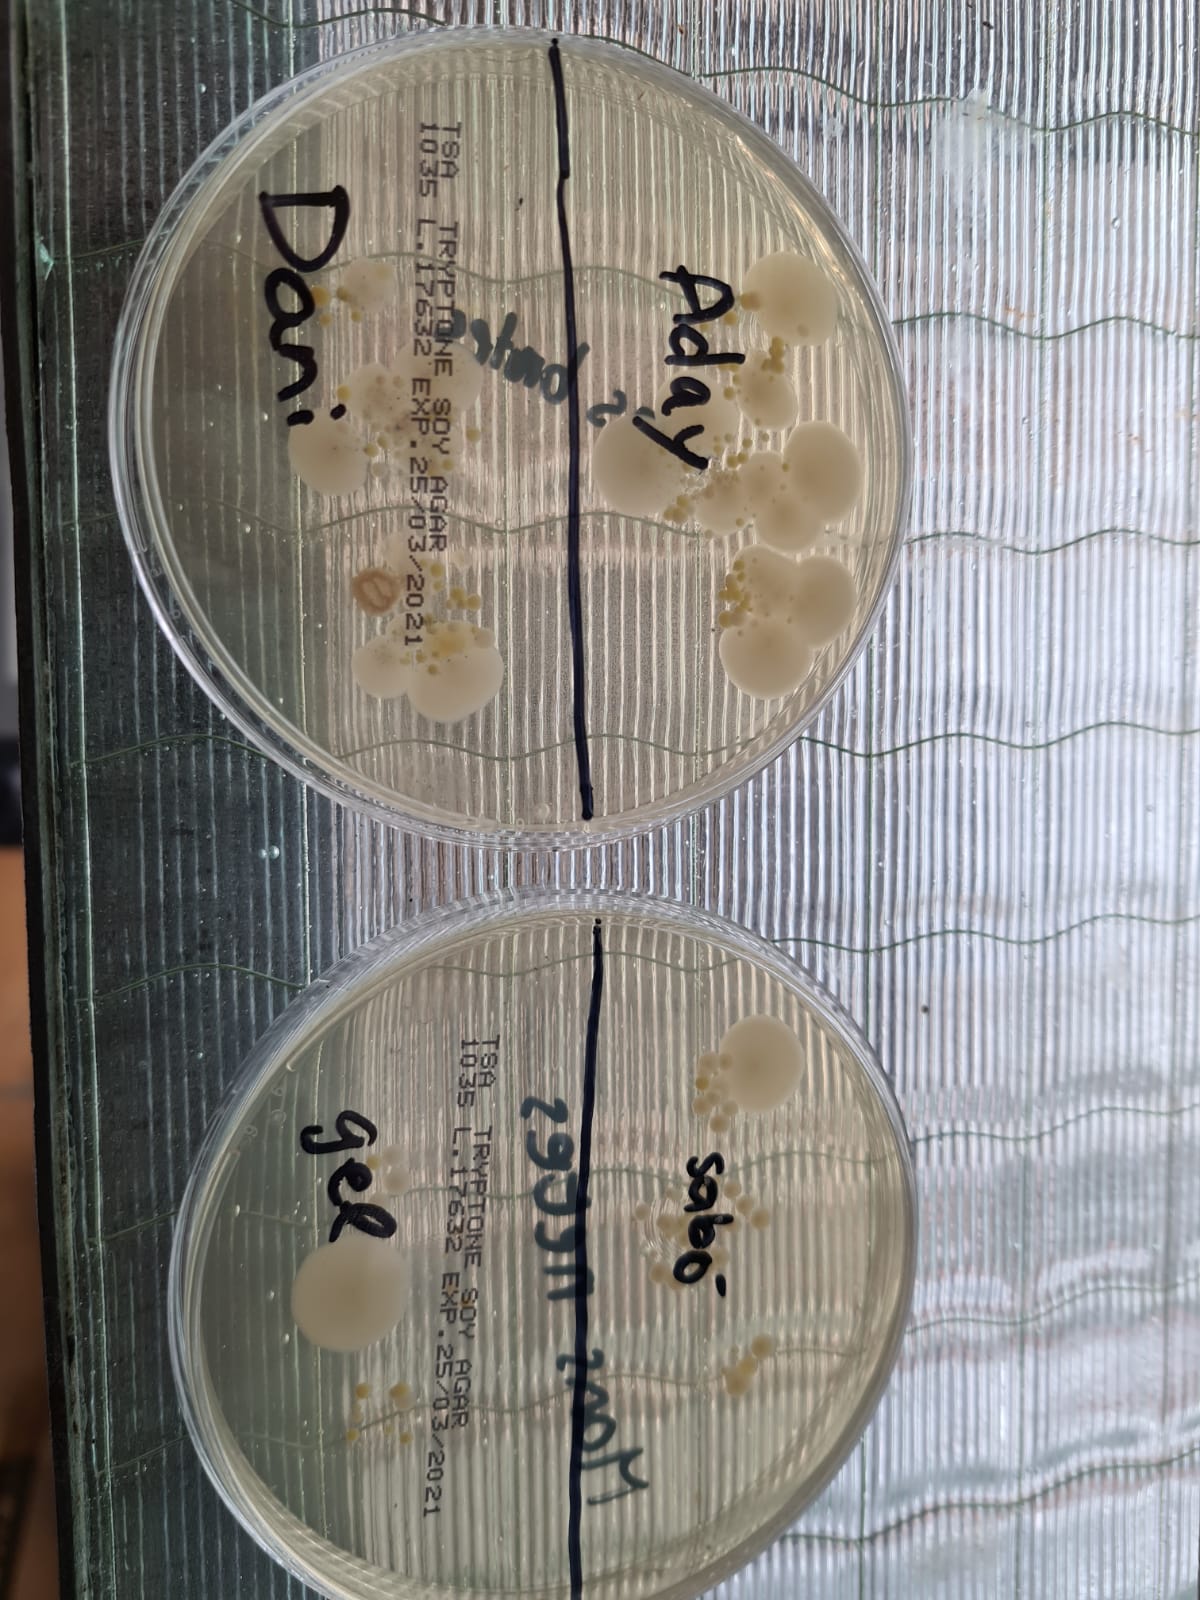

A l’assignatura de Ciències aplicades a l’activitat professional, els i les alumnes de 4t d’ESO hem pres consciència que estem envoltats de ciència. A través del mètode científic i el disseny experimental, hem treballat de manera dinàmica temes molt diversos tot tocant les diferents indústries (alimentària, química, farmacèutica, etc.).
Ens hem endinsat a la indústria alimentària elaborant iogurt, hem treballat els mètodes de conservació dels aliments experimentant amb el fenomen de l’osmosi i hem comprovat com diferenciar el pernil dolç “extra” del “fiambre” a través de la prova del lugol.
Dins del món de la salut i de la indústria farmacèutica hem elaborat un model de pulmons per veure l’efecte del tabac, ens hem preguntat i investigat com es dissol millor una aspirina i ens hem convertit en microbiòlegs dissenyant un experiment per comprovar si rentar-se les mans amb sabó i gel hidroalcohòlic elimina els microorganismes que tenim a les mans. També hem fabricat sabó a partir de l’estudi de la reacció de saponificació.
A més a més, hem treballat diferents temes de controvèrsia sociocientífica i hem fet debats sobre els aliments transgènics i les vacunes.
És essencial tenir uns coneixements científics mínims per tal de desenvolupar el nostre esperit crític envers la ciència!